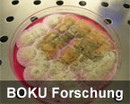

Aktuelle Meldungen

VIBT-Eröffnung im Web
Am 29. Oktober wurde das BOKU VIBT – Technologiezentrum in der Muthgasse 11 nach 2-jähriger Bautätigkeit eröffnet. Hier finden Sie Bilder, Zitate und Videos vom offiziellen Festakt und von den Fachgesprächen sowie vom neuen Gebäude.

Lust am Gestalten? Freude am Umgang mit Menschen? Engagiert?
Die ÖH Boku sucht neue MitarbeiterInnen in den verschiedensten Bereichen wie Bildungspolitik, Soziales oder EDV. Bewerbungen mit Lebenslauf und Motivationsschreiben können im Sekretariat abgeben werden oder per Mail an office@oehboku.at gesendet werden. Die Bewerbungsfrist endet am 19.10. 2009.

Gastprofessur Prof. James Bingen
Prof. James Bingen von der Michigan State University ist im Wintersemester 2009/10 Gastprofessor an der BOKU. Er liest „Ökologische Landwirtschaft, Politik und Gesellschaft: eine vergleichende und globale Perspektive“ (in englischer Sprache). Nähere Informationen: https://online.boku.ac.at/BOKUonline/lv.detail?clvnr=251710